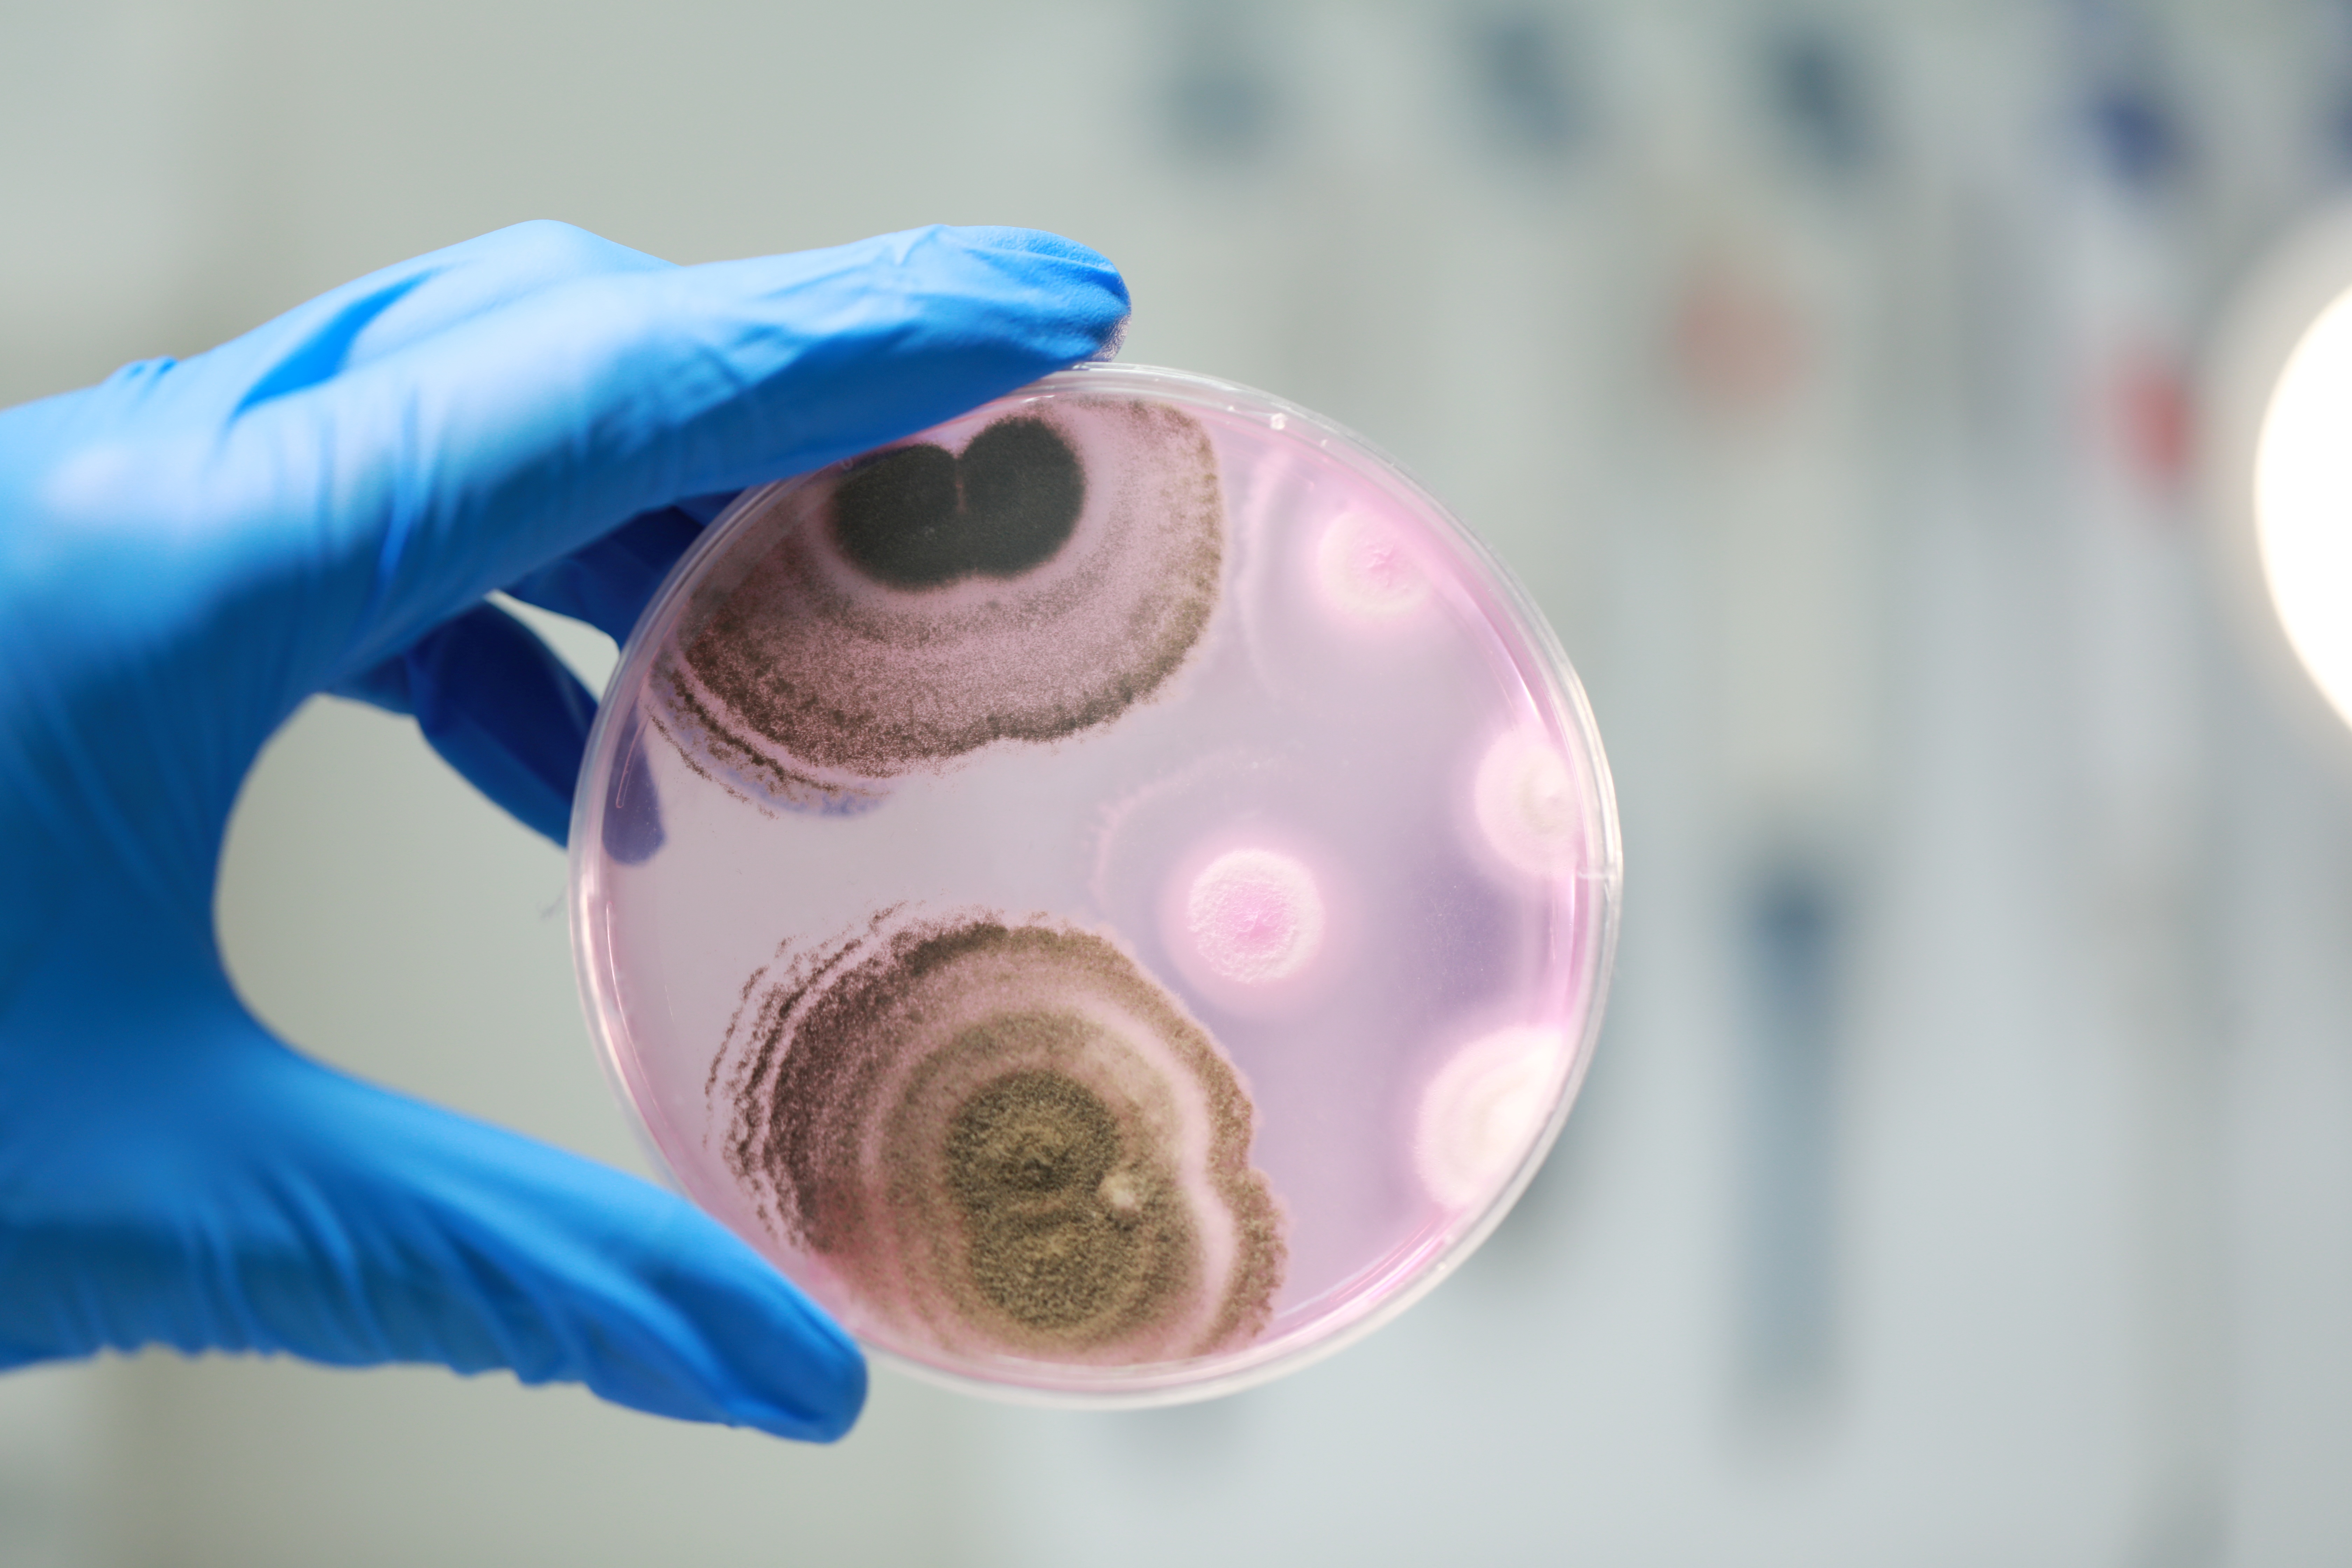

近日,世界知识产权组织(WIPO)公布了2025年全球奖30强名单,共有6家中国企业入围,其中广东一家企业入围。
据“WIPO中国”微信公众号消息,本次入围30强的6家中国企业,分别是慕恩(广州)生物科技有限公司(以下简称慕恩生物)、上海邦邦机器人有限公司、碳一新能源(杭州)有限责任公司、成都成华蝶舞华天文化旅游发展有限公司、陕西欧卡电子智能科技有限公司以及宇树科技有限公司。
据悉,WIPO全球奖自2022年设立,是目前全球知识产权领域的最高奖项,旨在表彰企业在知识产权布局、技术创新、社会价值创造上的卓越实力。今年,共有来自95个国家的780家企业参与竞争这一知识产权领域“奥斯卡”,脱颖而出的慕恩生物成为该奖项设立以来,首家入围30强的广州黄埔企业。
当前,新一轮科技革命和产业变革不断加剧,企业之间的竞争愈发成为知识产权的比拼。而每年评选一次的WIPO全球奖,便主要关注企业能否将知识产权转化为成功的商业运营、能否通过知识产权战略实现业务增长、能否有助于实现联合国可持续发展目标。
作为国内唯一入围的微生物科技企业,“WIPO中国”认为,慕恩生物最核心的创新亮点是能够利用合成生物学和微生物多样性,开发出能够促进植物生长、改善土壤健康、减少化学投入的微生物肥料,引领可持续农业的发展。

据了解,慕恩生物目前已经建立了全球规模最大、生物多样性最高的商业化菌种库,累计保存超过31万株具有自主知识产权的菌株,其中包括约15000株高价值菌株和6000多个新物种。已在全球提交专利申请209件,累计提交国际PCT专利申请23项,获得中国发明专利授权71项、澳大利亚授权2项及获得美国商标注册证2项。其独创的“菌株-工艺-制剂”三位一体保护模式,使单株高价值微生物平均拥有5项以上关联专利,构筑起立体化技术壁垒。
广州开发区、黄埔区始终将生物医药产业作为区域发展的重要抓手,从创新政策到营商环境,一切为企业着想。以“三城一岛”战略发展平台为依托,该区正全力构建研发在生物岛、中试在科学城、制造在知识城的全产业链闭环。
南方网、粤学习记者 何敏辉
通讯员 孙旭东










